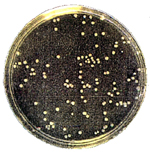

The Standard of Care
The "standard of care" changes as
health care
and nursing research determine the effectiveness of approaches
to care.
Hygenique
Plus ™ - The Standard of Care
Hygenique™ Sitz Bath
was designed by a nurse to promote wound healing, provide pain relief, and reduce
surface contaminants in the perineal area.
Promotes Wound Healing
Hygenique™ Sitz Bath's
continuous warm water cleansing therapy concentrates heat and stimulates blood
flow to the perineal wound or episiotomy. This local hyperthermia increases
subcutaneous perineal tissue temperature and oxygen tension, thus significantly
promoting the wound healing process.
Episiotomies
Fissures
Peri-anal abscesses
Anal lesions
Vaginectomies
Fistulas
Hemorrhoidectomies
Vaginal tears/trauma
Decreases Peri-anal Pain
By providing a gentle, therapeutic
cleansing and soak, as well as local hyperthermia to the perineal wound, the
patient will feel a relaxation of the internal an'al sphincter muscle, thus
decreasing pain due to perineal trauma.
Episiotomies
Itching
Incisions
Perineal trauma
Hemorrhoids
Burning
Chronic diarrhea pain
Pain from infections
Puritius ani
Reduces Surface Contaminants
Hygenique's glycerin cartridge
and warm water cleansing therapy gently debride loosely attached devitalized
tissues; reduce surface contaminants such as residual blood, urine, and fecal
matter; and provide a surfactant and emollient to help maintain the proper
PH level without drying out the tissue.
Chronic diarrhea
Reduces potential for skin breakdown which can
lead to infection for immune-suppressed patients
Incontinence
Reduces potential for infection
Reduces the risk of urinary-tract infections
References:
McCulloch, J. (1995). Physical
Modalities in Wound Management, Ultrasound, Vasopneumatic devices and Hydrotherapy.
Ostorny Wound Management, 41(5), 30-32, 34, 36-37.
Rabkin, J.M. and Hunt, T.K. (1987).
Local Heat Increases Blood Flow and Oxygen Tension in Wounds. Archives
of Surgery 122(2), 221-225.
Shafic, A- (1993). Warm-Water
Bath in Anorectal Conditions: The Thermosphincteric Reflex. Journal of Clinical
Gastroenterolo&L 16(4), 304-308.
APPLICATIONS HOSPITAL WIDE -
For Diagnoses and Procedures of the Perineum
Treatment
Postpartum
Gynecology
AIDS
Radiation / Oncology
Med-Surg
Voiding Stimulation
Pain Relief
Gastroenterology
Postpartum
AIDS
Med-Surg
Radiation / Oncology
Gynecology
Prevention
Preterm Births
Surgical Infections Perineum
Neonatal Infection
Nosocomial Diarrhea
Urinary Tract Infection
Treatment: Promotes Wound Healing
Hygenique™ Sitz Bath's
continuous warm water cleansing therapy concentrates heat and stimulates blood
flow to the perineal wound. This local hyperthermia increases subcutaneous
perineal tissue temperature and oxygen tension, thus significantly promoting
the wound healing process.
(1) Local Heat Increases Blood Flow and
Oxygen Tension in Wounds. Archives of SurgeEy, Rabkin, J.M. and
Hunt, T.K. (1987), pages 122 (2), 221-225.
(2) Physical Modalities
in Wound Management, Ultrasound, Pasopneumatic devices and Hydrotherapy.
Ostomy Wound Management, McCulloch, J. (1995). 41(5),30-32, 34,36-37.
(3) Minimizingjactors that impair wound
healing; a nursi . ng approach. Ostomy Wound Management, Krasner,
D., vol. 41, pages 22-6, 28, 30.
(4) Wound healing. Advanced Dermatology
Waldorf, H., 1995, vol. 10, pages 77-96; discussion 97. Department of
Dermatology, Harvard Medical School, Boston, MA.
(5) Using Wound Care products to promote
a healing environment. Critical Care NqE~jn North America.
Maklebust, J., June 1996, vol. 8, pages 141-158.
(6) Perineal manifestations
of HlV infection. Diseases Colon Rectum, Orkin, B.A-, April 1992,
vol. 4, issue 35. Division of Colon and Rectal Surgery, (5porge Washington
University Medical Center, Washington, D.C.
Pain Relief: Decreases Perineal Pain
Hygenique™ Sitz Bath
provides a gentle, therapeutic cleansing and soak, as well as local hyperthermia
to the perineal wound. The patient will feel a relaxation of the internal
anal sphincter muscle, thus decreasing pain.
(1) Warm-Water Bath in Anorectal Conditions:
The Thermosphincteric Reflex. Journal of Clinical GastroenterolozL
Shafic. A. (1993). 16(4), 304-308.
(2) Anal sphincter complex;
endoanal MR imaging of normal anatomy. Radiology Hussain, SM.,
Dec. 1995, vol. 197, pages 671-7. Department of Radiology,
University Hospital Rotterdam.
(3) Anorectal disorders;five
common causes ofpain, itching and bleeding. Postgraduate Medicine.
Metcalf, A., Nov. 1995, vol. 98, pages 81-4, 87-9, 92-4. Department
of Surgery, University of Iowa Hospitals and Clinics, Iowa City, Lk
Prevention: Reduces Surface Contaminants
Hygenique™ Sitz Bath's
glycerin cartridge and warm water cleansing therapy gently debride loosely
attached devitalized tissues; reduce surface contaminants such as residual
blood, urine, and fecal matter; and provide a surfactant and emollient to
help maintain the proper PH level without drying out the tissue.
(1) Bacterial vaginosis
in pregnancy: an approach for the 1990's. Obstetrics & Qynecology
Survey, 1995, vol. 50, pages 482-8. University of North
Carolina, Department of Obstetrics and Gynecology, Chapel Hill, USA-
(2) Risk of preterm
delivery in pregnant women with group B streptococcal urinary infections
or urinary antibodies to group B streplococcal and E. coli antigens. British
Journal Obstetrics Qynecology, McKenzie, H., Feb. 1994, vol. 101,
pgs. 107-13. Department of Obstetrics and Gynecology, Ninewells
Hospital, Dundee.
(3) Preterm labor. emerging
role ofgenital tract infections. Infectious Agents Diseases Dec.
1995, Andrew, W.W., vol. 4, pages 196-211. Department
of Obstetrics and Gynecology, University of Alabama at Birmingham.
(4) Effect of vaginalfluid
on adherence of type I piliated Escherichia coli to epithelial cells. Journal
of Infectious Disease, Gaffney, R-A, Dec. 1995, vol. 172, pages
1528-35. Department of Urology, Northwestern University Medical School,
Chicago, IIL.
(5) Role of warm water
bath in inducing micturition in postoperative urinary retention after anorectal
operations. Urology International, Shafik, A., 1993, vol.
50, pages 213-7. Department of Surgery and Research, Faculty
of Medicine, Cairo University, Egypt.
(6) Clinical and molecular
epidemiology ofsporadic and clustered cases ofnosocomial Clostridium difficile
diarrhea. American Journal Medicine Jan. 1996, Samore,
M.11, vol. 100, pages 32-40, Division of Infectious Diseases, New
England Deaconess Hospital, Harvard Medical School, Boston, MA.
COMPARISON OF PERSONAL
HYGIENE TECHNIQUES
A COMPARISON OF THE Hygenique
Plus ™ SITZ
BATH / BIDET
SYSTEM TO A PERI-BOTTLE, BAG-TYPE SITZ
BATH, AND PERSONAL
HYGIENE WIPES FOR PERINEAL CARE
Microbiology performed at:
PTI Technologies, Inc.
Newbury Park, California
Microbiologist: John A. Simonetti
Date of Report: July 14, 1997
Purpose of the Study
Vaginal infections often contain
bacteria that are normal inhabitants of the intestinal tract. Some of the
rnicro-organisms cited in literature most frequently are Escherichia coli
(E. Coli) and group B Streptococcus. These pathogens have been indicated as
one of the causes for urinary tract infections. By reducing the number of
types of bacteria in the perineal region, the number of pathogens will also
be reduced; and with thern, we believe that the probability for cross-contamination
of the vaginal area with bacteria is also reduced. This study was undertaken
to compare various hygiene practices for perineal care to see which is the
most effective in reducing the number of bacteria in the perineal region.
Introduction
Different perineal cleaning techniques
were used following bowel movements by a female test subject. Following the
personal hygiene technique, the perineal area was then rinsed using a squirt
bottle filled with a sterile solution containing nutrients to support the
growth of bacteria (TSB). This "post hygiene" wash liquid was allowed to fall
into a sterilized basin and was subsequently transferred to a sterile Erlenmeyer
flask, removed to a laboratory, and evaluated for the presence of micro-organisms.
The number of bacteria in the post-hygiene TSB wash signifies the efficacy
of the personal hygiene step; that is, the lower the bacteria numbers in the
post-hygiene wash liquid, the more effective the person hygiene technique.
Materials
|
QTY
|
Description
|
|
4
|
Flasks containing 250-ml
sterile tryptic soy broth (TSB)
|
|
18
|
Sterile tryptic soy agar
(TSA) Petri dishes
|
|
6
|
Sterile 500-ml -wide-mouth
Erlenmeyer flasks for sample collection
|
|
6
|
0.2 micron membranes
|
|
1
|
Premoistened towelette (Tucks
brand)
|
|
1
|
240-cc peri-bottle
|
|
1
|
HygeniqueTm Sitz Bath/Bidet
|
|
1
|
Conventional sitz bath
(Futuro)
|
|
8
|
Test tubes containing 9.9-ml
TSB for dilution
|
|
1
|
Incubator set at 37 degrees
Celsius
|
|
1
|
Autoclave
|
|
1
|
Vortex
|
|
1
|
47-nim filter funnel with
vacuum source
|
|
4
|
Sterile squirt bottles
|
|
4
|
Sterile containers for catching
wash solution
|
1.0 Perineal Wash Procedures
After a bowel movement, the subject was instructed
to perform one of the following procedures:
1.1 Wipe perineum from the front to the back
with toilet paper.
1.2 Wipe perineurn from the front to the back
with toilet paper. Follow with 250-ml of warm water applied from a peri-bottle.
1.3 Wipe perineum from the front to the back,
with toilet paper. Follow with the use of a personal hygiene (Tucks) moistened
towelette.
1.4 No toilet paper. Two minute warm water
wash applied with Hygenique™ Sitz Bath.
2.0 Evaluation of Washed Perineal Area
After each of steps 1 - 4 above,
a sterile wash bottle filled with a sterile TSB was used to spray the TSB
over the perineal area; and the TSB wash was collected in a sterile plastic
basin. The TSB wash was then transferred to a sterile screw cap Erlenmeyer
flask and transferred to the laboratory. Samples from each of the steps above
were evaluated for the presence of bacteria by using the following method:
2.1 100 - ml of the sample
was filtered through a sterilizing grade membrane filter, and the filter
was placed on the surface of the TSA in a Petri dish. The purpose of this
collection method was to collect bacteria from a large volume of liquid
in case the bacteria counts were very low. A 0.2 micrometer filter is capable
of collecting all bacteria on its surface, and the cells are capable of
growing into visible colonies suitable for counting purposes.
2.2. 1 - ml sample was removed
from the sample container, plated directly on the surface of the TSA Petri
dish, and spread using a sterile glass rod (standard spread plate technique).
The purpose of this and following dilutions is to achieve countable quantities
of bacteria, even if the levels are very high.
2.3 The original sample was diluted using a
100 - fold dilution in sterile TSB, and 0. 1 - ml was removed and plated
as in step 2.2.
3.0 Sitz Bath
Water Sample
After a bowel movement, the subject was instructed
to '%kripe the perineal area with toilet paper and perform one of the following
procedures:
3.1 Hygenique™ Sitz Bath
Sitz Bath / Bidet
3.2 Conventional bag-type sitz bath
After a ten-minute sitz bath, a water sample
was removed and evaluated for bacterial contamination. See test results
3.1 and 3.2
Results
The results are listed in Table
I and photographs of several of the sample dilutions in Figure 1. Wash procedures
1.1, 1.2, and 1.3 had very similar numbers of bacteria which were present
in concentrations of approximately 3 x 107. This data suggests
that there is not much difference between the cleaning methods of toilet paper
used alone, toilet paper used in conjunction with a peri-bottle, and toilet
paper used in conjunction with a personal hygiene wipe (50% witch hazel).
There was a very large reduction of bacteria, however, after the use of the
Hygenique™ Sitz Bath ( see
1.4 ). The bacteria numbers were approximately 100 times less than writh the
peri-bottle or personal hygiene wipe. This means that the quantity of bacteria
was reduced, by the Hygenique™ Sitz Bath,
not only two or three, or ten times, but over 100 times or two orders of magnitude.
Table 1: Bacteria Levels in
TSB Rinse Liquid after Personal Hygiene
|
Wash Procedure
|
Number of Bacteria (Colony-Forrriing
Units) |
| |
Estimated Total
Bacteria per: 100-ml TSB
|
0. 1 - ml
Undiluted
|
0. 1 - ml
1/100 Dilution
|
| 1.1 Toilet paper only
|
30,000,000
|
TNTC
|
300
|
| 1.2 Toilet paper and peri-bottle
|
10,000,000
|
TNTC
|
100
|
| 1.3 Toilet paper and personal
hygiene wipe |
24,000,000
|
TNTC
|
240
|
| 1.4
Hygenique™ Sitz Bath
only --no toilet paper |
112,000
|
112
|
2
|
| 3.1
Hygenique™ Sitz Bath
sitz water |
0
|
0
|
0
|
| 3.2 Bag-type sitz water |
1,000,000
|
TNTC
|
2
|
TNTC = too numerous to count
 |
Toilet Paper Only
0.1 ml perineal rinse liquid
number of bacteria : TNTC
( estimated total bacteria 30,000,000 3 X 10 7 )
|
 |
|
|
Toilet Paper
and Peri-Bottle
0.1 ml perineal rinse liquid
Number of Bacteria : TNTC
( estimated total bacteria 10,000,000 or 1 X 10 7 )
|
|
 |
Bag-Type Sitz
Bath water sample
0.1 ml perineal rinse liquid
number of bacteria : TNTC
( estimated total bacteria 1,000,000 1 X 106)
|
 |
|
|
Toilet Paper
and Personal Hygiene Wipe
0.1 ml perineal rinse liquid
Number of Bacteria : TNTC
( estimated total bacteria 24,000,000 or 2.4 X 10 6 )
|
|
 |
Hygenique
only no Toilet Paper
0.1 ml perineal rinse liquid
number of bacteria : 112
( estimated total bacteria 112,000 1.2 X 105)
|
 |
|
|
Hygenique
Sitz bath Water Sample
Number of Bacteria : 0
( estimated total bacteria 0 )
|
|
| |
NOTE:
Bacteria colonies were reduced by over 250
times with the use of Hygenique™ Sitz Bath
when compared to toilet paper alone.
Bacteria colonies were reduced by over 100
times with the use of Hygenique™ Sitz Bath
when compared to toilet paper and a peri-bottle.
Bacterial colonies were reduced by over 200
times with the use of Hygenique™ Sitz Bath
when compared to toilet paper and a personal hygiene wipe.
Bacteria colonies were not detected
w th the use of the Hygenique™ Sitz Bath
Sitz Bath System.
Conclusion
Although these results only come
from a single test subject, they show conclusively that some personal hygiene
techniques are significantly more effective than others. Much of the logic for
understanding the mechanisms of how Hygenique™ Sitz Bath
works is simple common sense. The water mechanically removes debris and bacteria.
The results show particularly that the Hygenique™ Sitz Bath
is more effective than a peri-bottle, personal hygiene wipe ( 5 0% witch hazel
) and conventional sitz bath in removing microorganisms from the perineal area.
A reduction in bacteria from this area reduces the probability of cross-infection
to the vaginal area with enteric pathogens. Although this study did not differentiate
between enteric and normal inhabitants of the skin, it does show that the total
number of bacteria was reduced; and we hypothesize that enteric organisms as
well non-nal flora would be reduced in numbers with the use of
Hygenique™ Sitz Bath.
The Hygenique™ Sitz Bath
Sitz Bath water was notable in that there was no detectable bacteria present
( 3. 1 ). This is likely due to the presence of chlorine in the tap water and
that the water is constantly being replaced with new fresh clean water. The
conventional sitz bath water, however, did contain a large number of bacteria;
i.e., over a million. This discounts the fact that chlorinated water alone killed
the bacteria in the Hygenique™ Sitz Bath
Sitz Bath ( 3. 1 ); the replenished fresh water was probably responsible for
the killing or removing of the microorganisms.
Bibliography: available upon request.
TECHNOLOGY ASSESSMENT FOR PERINERAL CARE
with Emphasis on the Postpartum Period
and the Effect on Patient Outcomes
Submitted by:
Andermac,, Inc.
Yuba City, California
Manufacturer of
Hygenique Plus Sitz Bath/Bidet
Introduction
The following information will
give the researcher an overview of some of the common practices that are currently
being used in the treatment of perineal, trauma/care and their drawbacks to
patient care/outcomes. As part of the discussion, we will introduce the new
standard of care, the Hygenique
Plus ™
Sitz Bath/Bidet, a superior perineal cleansing and wound treatment system.
With the information presented in this package, you will be better informed
to make a decision based on medical, clinical, and laboratory testing when choosing
a treatment system for perineal care.
Desired Outcomes for Perineal Care
1. Provide a cleansing method which will reduce
surface contaminants' to help in the prevention of infection.
2. Provide a wound treatment system to help
promote the wound healing process.
3. Provide pain relief.
4. Provide the patient with a method to help
stimulate voiding before catheterization.
5. Provide the patient with an effective method
of treatment to continue perineal care throughout his/her recovery period.
6. Provide the standard of care
Common Practices for Perineal Care and Their Associated
Problems
1. Hygiene Wipes ( premoistened towelettes )
- Not eftective in removing a sufficient number
of surface contaminants'.
- No reduction in perineal pain.
- Does not promote wound healing.
- Does not stimulate voiding.
- Does not meet the Standard of Care.
2. Community Sitz Bath (tub approx.
3x3 ft., water delivered to patient at a steady flow)
- There is a potential for cross contamination
when using a community sitz bath, and the nurse must make sure that the bath
is thoroughly disinfected before each use.
- Potential for vasodilation (since a larger portion
of the patient's body is being heated).' Availability becomes a problem. If
there are several patients in line for treatment, the patient may have to
wait for treatment since most postpartum floors only have one or two sitz
bath rooms.
- More nursing time used with the operation of
a cornmunity sitz bath (disinfection, set-up, and nurse must monitor patient
since dizziness and fainting are often associated with the use of this system).
- Patient's concerns over using a community sitz
bath and privacy are a consideration. Patient cannot use this system upon
discharge.
3. Peri-Bottle (squirt bottle,
holds 240-cc)
- Not effective in removing a sufficient number
of surface contaminants.
- Does not provide wound healing.
- Does not provide pain relief
4. Bag-Type Sitz Bath (plastic basin, hooks up
to plastic bag holding approx. 2000-cc gravity feed 5 ft.)
- Potential for cross contamination; patient soaks
in his or her own contaminants which could lead to urinary tract infection
or other perineal infection.
- No method for removal of contaminants during
treatment; i.e., blood, urine, fecal matter.
- Treatment time cannot be met due to the cooling
of the bath water.
- A bag-type sitz bath cannot provide sufficient
water flow for a wtirlpool treatment if the bag is placed 4.5 feet above the
sitz bath. The maximum water pressure will only be about 1.5 psi of water
pressure.
- More nursing time usedi in the operation of
a bag-type sitz bath. Nurse must set up and remove the bag-type sitz for the
patient.
5. Whirlpool Tubs (bathtubs with water jets to provide
whirlpool action)
- Potential for cross contamination, urinary tract
infection.
- Do not provide local concentrated heat to the
perineal area; therefore, local hyperthermia is not achieved.
- Perineal pain is not reduced because of the
inability to achieve local hyperthermia.
- Potential for vasodilation.
- Nursing time increases,with the use of whirlpool
tubs (set-up time, nurse must monitor patient since dizziness and fainting
are often associated with the use of this system).
6. lce Packs (ice or cold gel wrapped in sealed pouch)
- Do not remove surface contaminants.
- Are only prescribed for the first 12 hours post
delivery.
- Do not promote wound healing.
- Do not stimulate voiding.
7. Anesthetic Sprays and Ointments (topical products
containing an anesthetic)
- Do not remove surface contaminants.
- Do not promote wound healing.
- Do not stimulate voidina.
Hygenique
Plus ™
The Hygenique
Plus ™ personal whirlpool sitz bath/bidet system
prevents cross-contamination and allows for treatment of perineal trauma such
as postepisiotomy edema, hemorrhoids, and pain in the perineurn and anal areas
both in the hospital and at home. This system easily connects to a single-spouted
water faucet for home use or to a delivery system in the patient's room. Used
as a whirlpool sitz bath, the unit provides continuous water-flow heat therapy
at a constant temperature and relief for tender tissues. With the flow-through
door, the unit may be used as a bidet for self-administered gentle cleansing.
The Hygenique Plus ™
is the only sitz bath system available that provides the
patient with contaminant-free soaking.
Hygenique
Plus ™
was designed to promote wound healing, provide pain relief, and reduce surface
contaminants in the perineal area.
Promotes Wound Healing
Hygenique™ Sitz Bath's
continuous warm water cleansing therapy concentrates heat and stimulates blood
flow to the perineal wound. This local hyperthermia increases subcutaneous perineal
tissue temperature and oxygen tension, thus significantly promoting the wound
healing process.
Decreases Perianal Pain
Hygenique™ Sitz Bath
provides a gentle, therapeutic cleansing and soak, as well as local hyperthern-~a
to the perineal wound. The patient will feel a relaxation of the internal anal
sphincter muscle, thus decreasing pain.
Reduces Surface Contaminants
Hygenique™ Sitz Bath's
glycerin cartridge and warm water cleansing therapy gently debride loosely attached
devitalized tissues; reduce surface contaminants such as residual blood, urine,
and fecal matter; and provide a surfactant and emollient to help maintain the
proper pH level without drying out the tissue.
Hygenique
Plus ™
Benefits
- reduces potential for infection by reducing
surface contaminants
- provides surfactant and emollient during cleansing
cycle
- debrides loosely attached devitalized tissue
- maintains proper pH level without drying out
tissue
- provides gentle-cleansing
- provides local hyperthermia
- stimulates blood flow
- increases perineal tissue temperature
- increases oxygen tension o relaxes internal
anal sphincter muscle, thus decreasing pain
- can be used in the hospital or at home
- requires less nursing time set up (patients
can use product without the help of a nurse)
- no potential for cross contamination since each
patient has his/her own sitz bath system
- local heat is delivered to perineal tissue,
reducing the risk for vasodilation
- patient is not forced to wait in line for sitz-bath
room and can maintain privacy
- patient can continue treatment at home with
the take-home system
Postpartum Nursing Care Practices: Perineal Trauma
Episiotomy/Perineal Swelling, Bruising
- Assess presence, location, and nature of
perineal discomfort.
|
Nursing Interventions
|
Rationale
|
| Use sitz baths (100-104 F) for
15 to 20 minutes three to four times a day. |
Heat increases circulation to
the perineum, thereby promoting oxygenation and nutrition of tissues. It,
therefore, promotes healing, which reduces discomfort. |
| Cleanse perineal area after each
elimination. |
Perineal cleansing reduces risk
for infection, which causes discomfort.
Cleansing from front to back reduces
introduction of intestinal-tract microorganisms.
|
| *Wash hands before and after perineal care,
elimination, and use of heat |
Cleansing the hands reduces microorganisms,
which could be transferred to the perineum. |
Hemorrhoids
- Assess for hemorrhoids and institute measures
to relieve pain. Hemorrhoids cause
discomfort and may interfere with elimination.
|
Nursing Interventions
|
Rationale
|
| Instruct client
in taking a warm sitz bath for 15 to 20 minutes three times a day. |
Warm sitz baths
and cleansing warm water sprays are helpful for relieving pain and
discomfort due to hemorrhoids. A sitz bath
temperature of 105'F is comfortable for most
women, although the patient's personal preferenceshould
be followed. Sitting in the bath for about 20
minutes is usually adequate for most patients. If
the patient uses a sitz tub rather than a personal sitz bath
system, use caution when assisting her out of
the tub; the warmth of the bath may causesufficient vasodilation, which
increases the risk for dizziness or fainting. |
- The use of a bidet system for perineal
cleansing helps prevent hand contamination and reduces the risk of cross contamination
by the hands to other parts of the body.
Risk for Uterine Infection (Endometritis) Related to:
- Ascension of microorganism into uterus
- Ineffective perineal care
The most common pathogens responsible
for postpartum infections are those that inhabit the lower genital tract and
bowel; however, pathogens may also be exogenous in nature. After birth, portads
of entry for bacterial invasion include the placental site, the perineum, the
episiotomy, an incision or laceration, the vagina~ the urinary tract, the breast,
and the lymphatic system along the uterine veins. Common organisms include Streptococcus,
Escherichia coli, Staphlococcus, Clostridia, Klebsiella, and Neisseria
gonorrhoeae. Most infections are caused by a combination of anaerobic bacteria.
Risk for Urinary Tract Infection Related to:
- Incomplete emptying of bladder
- Perineal swelling, discomfort
- Trauma to the bladder
- Inappropriate wiping technique
|
Nursing Interventions
|
Rationale
|
|
The patient should be taught
self-care measures to reduce the risk for infection. This includes teaching
her to ,vNipe the perineum from front to back after voiding and defecation.
This decreases the risk for contamination with microorganisms from the
anus to the vagina. Warm water using a bidet or other irrigator device
should be used to rinse the perineum after elimination.
|
Frequent assessment of bladder
distention is essential during the postpartum period. Catheterization
should be used only after other interventions have proven unsuccessful,
because catheterization increases the risk for bladder infection.
|
|
Run water, pour warm water
over perineum, or have patient void in shower.
|
With trauma, swelling, and
decreased distention, there is a tendency toward urinary retention. Urinary
retention increases the risk for infection. The patient should void at
least I 00-rnl per voiding. With trauma and urinary tract changes, the
bladder may become distended. In addition, renal plasma flow remains elevated
in the first week after delivery, which increases bladder filling.
(Nichols 1997; Zwelling 1997)
|
Risk for Infection: Vagina, Episiotomy/Perineum, Breasts
(Mastitis) Related to:
- Lacerations
- Trauma to perineum
- Episiotomy
- Handling of breasts, breast-feeding
|
Nursing Interventions
|
Rationale
|
|
Educate patient in how to
do perineal cleansing. This includes cleansing from front to back and
rinsing with water after each elimination.
|
Cleansing the perineum reduces
the number of microorganisms present. In addition, it removes lochia,
moisture that provides an environment favorable for the growth of microorganisms.
|
|
Instruct client to wash hands
before and after perineal cleansing and changing perineal pads.
|
Washing hands reduces microorganisms
that can be introduced to perineal pads or the perineum.
|
|
Instruct patient to use a
sitz bath or apply hot packs for 15 to 20 minutes three times a day.
|
Warm heat increases circulation,
which promotes healing. It also reduces discomfort.
|
|
Instruct patient to wash hands
before breast-feeding.
|
Milk ducts open directly
onto nipple. Microorganisms on the hands may be introduced into the breasts
through handling associated with breast-feeding.
|
- The use of a bidet system for perineal
cleansing helps prevent hand contamination and reduces the risk of cross contamination
by the hands to other parts of the body.
Hygenique™ Sitz Bath
Applications - For Diagnoses and Procedures of the
Perineum
- Episiotomies
- Fissures
- Perineal abscesses
- Anal lesions
- Vaginectomies
- Fistulas
- Hemorrhoidectomies
- Vaginal tears/trauma
- Episiotomies
- Itching
- Incisions
- Perineal trauma
- Hemorrhoids
- Burning
- Chronic diarrhea pain
- Pain from infections
- Perineal hematoma
- Puritius ani
- Perineal swelling
- Chronic diarrhea hygiene
- Reduces the risk of urinary-tract infections
- Incontinence
- Reduces potential for infection
- Reduces the risk for uterine infection (endometritis)
- Reduces potential for skin breakdown which can
lead to infection for immune- suppressed patients
Hospital/Departments
- Postpartum
- Gynecology
- Gastroenterology
- Infection Control
- AIDS Ward
- Radiation/Oncology
- Med-Surg
- Hospital-wide (voiding stimulation)
Incentives to Change Current Practice
- Meet the Standard of Care
- Better Patient Outcomes
- Financial Outcomes
- Better Clinical Outcomes
- Improved Continuity of Care
The Standard of Care
The "standard of care" changes
as health care and nursing research determine the effectiveness or ineffectiveness
of approaches to care. Hospital policies and procedures set standards of care.
The standard of care is expected to be based on the professional literature
and reviewed at regular intervals so that they remain current.
(Nichols 1997; Zwelling 1997)
Conclusion
This technology assessment has included references
from various technical publications, professional literature, textbooks, university
studies, and laboratory testing. The information presented clearly shows the
benefits that Hygenique Plus ™
, the new standard of care, can have on patient care/outcomes.
References
Comparison of Hygenique Plus
Sitz Bath Bidet to a peri-bottle, bag-type sitz bath and personal hygiene
wipes for perineal care. Simonetti, J.A., July 1997, PTI Technologies,
Newbury Park, CA.
Maternal-Newborn Nursing: 7heory and Practice.
Nichols, F.H. and Zwelling, E., 1997. W.B. Saunders Company.
Local Heat Increases Blood Flaw and Oxygen
Tension in Wounds. Archives of Surge1y Rabkin, J.M. and Hunt, T.K.
(1987), pgs. 122 (2), 221-225.
Physical Modalities in
Wound Management, Ntrasound, Vasopneumatic Devices and Hydrotherapy. Ostomy
Wound Management, McCulloch, J. (1995), pgs. 41 (5)) 30-32, 34, 36-37.
Minimizing jactors that impair wound healing;
a nursing approach. OstomyWound Management, Krasner, D., vol. 41,
pgs. 22-6, 28, 30.
Wound healing. Advanced Dermatology,
Waldorf, H., 1995, vol. 10, pgs. 77-96; discussion 97. Department of Dermatology,
Harvard Medical School, Boston, MA.
Using Wound Care products to promote a
healing environment. Critical Care Nursing North America, Maklebust,
J., June 1996, vol. 8, pgs. 141-158.
Perineal manifestations
of HIV infection. Diseases Colon Rectum, Orkin, B.A., April 1992,
vol. 4, issue 35. Division of Colon and Rectal Surgery, George Washington
University Medical Center, Washington, D.C.
Effect of vaginal fluid on
adherence of type l piliated Escherichia coli to epithelial cells. Journal
of Inffectious Diseases Gaffhey, R.A., Dec. 1995, vol. 172, pgs. 1528-35.
Department of Urology, Northwestern University Medical School, Chicago, IL.
Role of warm water bath in
inducing micturition in postoperative urinary retention after anorecial operations.
Urology International, Shafik, A., 1993, vol. 50, pgs. 213 -7.
Department of Surgery and Research, Faculty of Medicine, Cairo University,
Egypt.
Clinical and molecular epidemiology
of sporadic and clustered cases of nosocomial Clostridum difficile diarrhea
American Journal Medicine, Jan. 1996, Samore, M.H., vol. 100, pgs.
32-40, Division of Infectious Diseases, New England Deaconess Hospital, Harvard
Medical School, Boston, MA.
Warm-Water Bath in Anorectal
Conditions: The Thermosphincteric Reflex. Journal of Clinical Gastroenterology
Shafic, A. (1993). 16(4), 304-308.
Anal sphincter complex; endoanal MR imaging
of normal anatomy. RadiologyHussain S.M., Dec 1995, vol. 197, pgs.
671-7. Department of Radiology, University Hospital Rotterdam.
Anorectal Disorders, five
common causes of pain, itching and bleeding. Postgraduate Medicine.
Metcalf, A., Nov. 1995, vol. 98, pgs. 81-4, 87-9, 92-4. Department of
Surgery, University of Iowa Hospitals and Clinics, Iowa City, IA.
The virulence of E. Coli strains
isolated in urinary infections. Bacteriology Virology Parasitology
& Epidemiology. David, E., Jan. 1993, vol. 41, pgs. 57-61.
Episiotomy and body image. Modern Midway,
Sept. 1996, vol. 6, pgs. 18-19.
Factors related to perineal trauma in childbirth.
Journal of Nurse Midwifery Jul.Aug. 1996, vol. 41, pg. 269.
An overview of urinary incontinence
in adults: assessments and behavioral interventions. Clinical Nursing
Specialty, Beckman, N.J., Sept. 1995, vol. 9, pgs. 241-7, 274.
Anorectal disorders. Emergency
Medical Clinician North America, Janicke, D.M., vol. 14, pgs. 757-88.
Department of Emergency Medicine, State University of New York at Buffalo,
Millard Filhnore Hospital.
Anal Itching: Strategies to
Stop the Scratching. Fleiss, P.M., M.D., Universily of Southern California
School of Medicine.
NRS 414 Research Utilization. Rosenfeld,
A. RN, PhD., 1994, University of Portland School of Nursing .